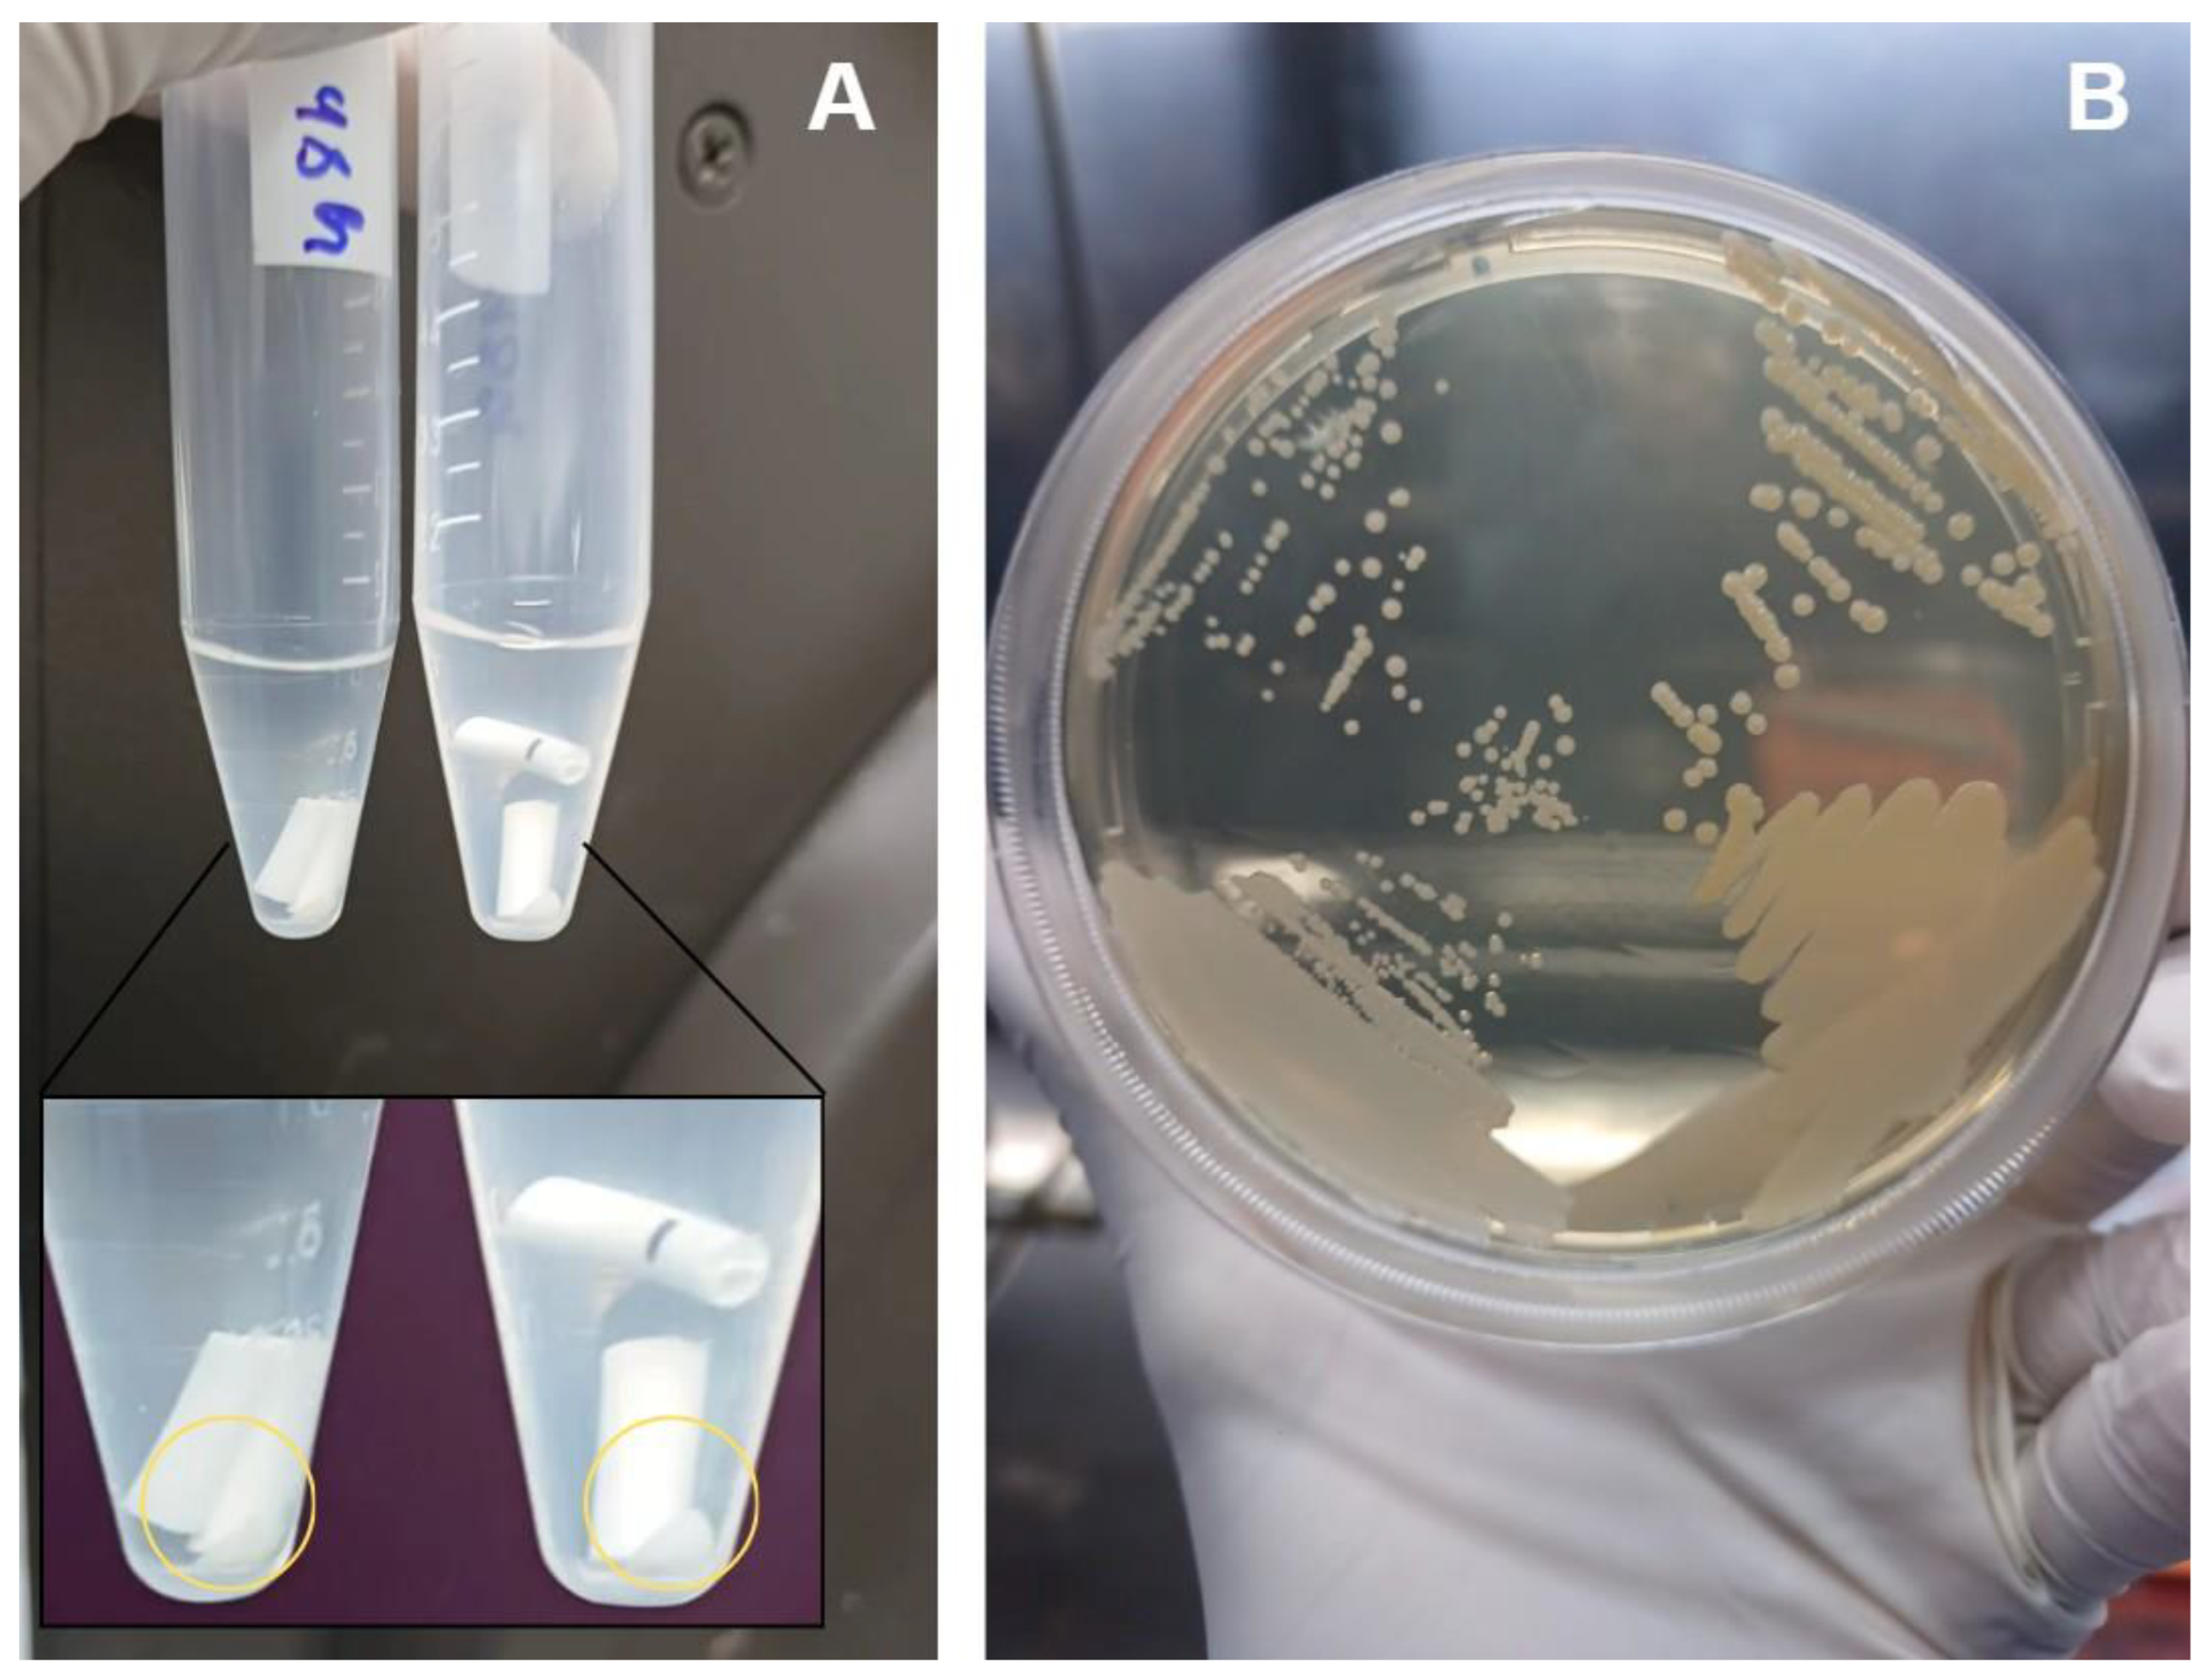
Preprints 189127 g004

Submitted:
10 December 2025
Posted:
12 December 2025
You are already at the latest version
Abstract
Background/Objectives: Periprosthetic joint infections (PJIs) remain one of the most challenging complications after arthroplasties due to the ability of pathogens to form biofilms on implant surfaces. Although staphylococci predominate, Gram-negative bacilli, have increasingly been associated with more aggressive clinical courses and diagnostic failure. This study aimed to evaluate the structural characteristics and maturation of E. coli and P. aeruginosa biofilms and to assess the effectiveness of a standardized sonication protocol in disrupting these biofilms and releasing viable cells. Methods: Biofilms of E. coli (ATCC 25922) and P. aeruginosa (ATCC 53278) were grown on polyethylene catheter segments for 24, 48, and 72 hours. Morphological and structural features were assessed by scanning electron microscopy. A standardized sonication protocol was then applied to evaluate its ability to disrupt the extracellular polymeric matrix. Viability of released cells was confirmed by culturing aliquots of the sonication fluid on BHI agar. Biofilms were produced in triplicate for each time point. Results: Both species formed increasingly dense and structured biofilms over time. Mature biofilms exhibited markedly thicker EPS layers compared to 24-h biofilms. P. aeruginosa developed highly complex, multilayered matrices, while E. coli produced characteristic but less elaborate biofilm structures. Sonication consistently disrupted immature and mature biofilms of both organisms, fragmenting the matrix and releasing individual or small clusters of bacterial cells. Cultures from the sonication fluid demonstrated that bacterial cells remained viable following the procedure. Conclusions: The standardized sonication protocol effectively disrupted Gram-negative biofilms at different maturation stages and released viable microorganisms, reinforcing its value as a complementary diagnostic tool for PJIs, especially in chronic or low-grade infections where conventional culture methods show reduced sensitivity.
Keywords:
1. Introduction
2. Results
2.1. Temporal Development and Maturation of Bacterial Biofilms
2.2. Effect of Sonication on Biofilm Disruption
3. Discussion
4. Materials and Methods
4.1. Bacterial Strains and Rationale for Their Selection
4.2. Biofilm Formation and Experimental Design
4.3. Sonication Protocol
4.4. Recovery of Viable Bacteria After Sonication
4.5. Scanning Electron Microscopy (SEM)
5. Conclusions
Supplementary Materials
Author Contributions
Funding
Institutional Review Board Statement
Informed Consent Statement
Data Availability Statement
Acknowledgments
Conflicts of Interest
References
- Trebše R.; Roškar S. Evaluation and interpretation of prosthetic joint infection diagnostic investigations. Int Orthop 2021, 45(4):847–855. [CrossRef]
- Romero I.F.; Nieto A.R. Procesamiento de muestras osteoarticulares para diagnóstico microbiológico: resultados de una encuesta multicéntrica nacional. Enferm Infecc Microbiol Clin 2021, 1–5. [CrossRef]
- Zimmerli W.; Sendi P. Orthopaedic biofilm infections. APMIS 2017, 125(4):353–364. [CrossRef]
- Flemming H.-C.; Wingender J.; Szewzyk U.; Steinberg P.; Rice S.A.; Kjelleberg S. Biofilms: an emergent form of bacterial life. Nat Rev Microbiol 2016, 14(9):563–575. [CrossRef]
- Vrancianu C.O.; Serban B.; Gheorghe-Barbu I.; Czobor Barbu I.; Cristian R.E.; Chifiriuc M.C.; Cirstoiu C. The challenge of periprosthetic joint infection diagnosis: from current methods to emerging biomarkers. Int J Mol Sci 2023, 24(5):4320. [CrossRef]
- Sebastian S.; Malhotra R.; Sreenivas V.; Kapil A.; Chaudhry R.; Dhawan B. Sonication of orthopaedic implants: a valuable technique for diagnosis of prosthetic joint infections. J Microbiol Methods 2018, 146:51–54. [CrossRef]
- Karbysheva S. Comparison of sonication with chemical biofilm dislodgement methods using chelating and reducing agents: implications for the microbiological diagnosis of implant-associated infection. J Am Acad Orthop Surg Glob Res Rev 2021, 5(11). [CrossRef]
- Bellova P.; et al. Sonication of retrieved implants improves sensitivity in the diagnosis of periprosthetic joint infection. BMC Musculoskelet Disord 2019, 20:623. [CrossRef]
- Trampuz A.; Piper K.E.; Jacobson M.J.; Hanssen A.D.; Unni K.K.; Osmon D.R.; et al. Sonication of removed hip and knee prostheses for diagnosis of infection. N Engl J Med 2007, 357:654–663. [CrossRef]
- Oliva A.; Pavone P.; D’Abramo A.; Iannetta M.; Mastroianni C.M.; Vullo V. Role of sonication in the microbiological diagnosis of implant-associated infections: beyond the orthopedic prosthesis. Adv Exp Med Biol 2016, 897:85–102. [CrossRef]
- Silva N.D.S.; De Melo B.S.T.; Oliva A.; de Araújo P.S.R. Sonication protocols and their contributions to the microbiological diagnosis of implant-associated infections: a review of the current scenario. Front Cell Infect Microbiol 2024, 14:1398461. [CrossRef]
- Scalia A.C.; Najmi Z. Targeting bacterial biofilms on medical implants: current and emerging approaches. Antibiotics 2025, 14:802. [CrossRef]
- Cieslinski J.; Ribeiro V.S.T.; Kraft L.; Suss P.H.; Rosa E.; Morello L.G.; Pillonetto M.; Tuon F.F. Direct detection of microorganisms in sonicated orthopedic devices after in vitro biofilm production and different processing conditions. J Bone Joint Infect 2021, 6(2). [CrossRef]
- Macias-Valcayo A.; Aguilera-Correa J.-J.; Broncano A.; Parron R.; Auñon A.; García-Cañete J.; Blanco A.; Esteban J. Comparative in vitro study of biofilm formation and antimicrobial susceptibility in Gram-negative bacilli isolated from prosthetic joint infections. Microb Drug Resist 2023, 29(6):700–709. [CrossRef]
- Thompson J.M. Mouse model of Gram-negative prosthetic joint infection reveals therapeutic targets. Antimicrob Agents Chemother 2021, 65:e02066-20. [CrossRef]
- Moon Y.; Hong J.; Choi S.; Kim H.; Sohn H.M.; Jo S. Biofilm growth on different materials used in contemporary femoral head prosthesis: an in vitro study. J Orthop Res 2022, 40:1–9. [CrossRef]
- Benito N.; et al. Time trends in the etiology of prosthetic joint infections: a multicenter cohort study. Clin Microbiol Infect 2024, 30(4):547–554. [CrossRef]
- Fantoni M.; Borrè S.; Rostagno R.; Riccio G.; Carrega G.; Giovannenze F.; Taccari F. Epidemiological and clinical features of prosthetic joint infections caused by Gram-negative bacteria. J Infect 2023, 86(5):531–539. [CrossRef]
- Gonzalez M.R.; Gonzalez J.; Patel R.V.; Werenski J.O.; Lizcano J.D.; Lozano-Calderon S.A.; Gram-negative PJI Collaborative Group. Microbiology, treatment, and postoperative outcomes of Gram-negative prosthetic joint infections: a systematic review. J Am Acad Orthop Surg 2025, 33(6):e327–e339. [CrossRef]
- Zouitni A.; van Oldenrijk J.; Bos P.K.; Croughs P.D.; Yusuf E.; Veltman E.S. Evaluating the clinical relevance of routine sonication for periprosthetic hip or knee joint infection diagnosis. Antibiotics 2024, 13(4):366. [CrossRef]
- Fernández-Sampedro M.; Fariñas-Álvarez C.; Garcés-Zarzalejo C.; et al. Accuracy of different diagnostic tests for early, delayed and late prosthetic joint infections. BMC Infect Dis 2017, 17:592. [CrossRef]
- Zouitni A.; Bos P.K.; Vogel M.; Croughs P.; Slobbe L.; Claus P.E.; van Oldenrijk J.; Veltman E.S.; Yusuf E. Impact of sonication fluid cultures on prosthetic joint infection diagnosis and management: a microbiology-driven evaluation using IDSA and EBJIS criteria. Clin Infect Dis 2025, 391. [CrossRef]
- Sandbakken E.T.; Witsø E.; Sporsheim B.; Egeberg K.W.; Foss O.A.; Hoang L.; Bjerkan G.; Løseth K.; Bergh K. Highly variable effect of sonication to dislodge biofilm-embedded Staphylococcus epidermidis directly quantified by epifluorescence microscopy: an in vitro model study. J Orthop Surg Res 2020, 15:522. [CrossRef]
- Schweizer T.A.; Egli A.; Bosshard P.P.; Achermann Y. Saponin improves recovery of bacteria from orthopedic implants for enhanced ex vivo diagnosis. Microorganisms 2025, 13:836. [CrossRef]
- Hoekstra M.; Veltman E.S.; Nurmohamed R.F.R.H.A.; van Dijk B.; Rentenaar R.J.; Vogely H.C.; van B.C.H. Sonication leads to clinically relevant changes in treatment of periprosthetic hip or knee joint infection. J Bone Joint Infect 2020, 5:128–132. [CrossRef]
- Peng G.; Liu Q.; Guan Z.; et al. Diagnostic accuracy of sonication fluid cultures from prosthetic components in periprosthetic joint infection: an updated diagnostic meta-analysis. J Orthop Surg Res 2023, 18:175. [CrossRef]
- Otero J.A.; Karau M.J.; Greenwood-Quaintance K.E.; Abdel M.P.; Mandrekar J.; Patel R. Evaluation of sonicate fluid culture cutoff points for periprosthetic joint infection diagnosis. Open Forum Infect Dis 2024, 11(5):ofae159. [CrossRef]
- Li C.; Renz N.; Ojeda Thies C.; Trampuz A. Meta-analysis of sonicate fluid in blood culture bottles for diagnosing periprosthetic joint infection. J Bone Joint Infect 2018, 3(5):273–279. [CrossRef]
- Yuan Q.; Karau M.J.; Greenwood-Quaintance K.E.; Mandrekar J.N.; Osmon D.R.; Abdel M.P.; Patel R. Comparison of diagnostic accuracy of periprosthetic tissue culture in blood culture bottles to prosthesis sonicate fluid culture by Bayesian latent class modelling and IDSA PJI criteria. J Clin Microbiol 2018, 56(6):e00319-18. [CrossRef]
- Beguiristain I.; Henriquez L.; Sancho I.; Martin C.; Hidalgo-Ovejero A.; Ezpeleta C.; Portillo M.E. Direct prosthetic joint infection diagnosis from sonication fluid inoculated in blood culture bottles by direct MALDI-TOF mass spectrometry. Diagnostics 2023, 13(5):942. [CrossRef]
- Li C, Renz N, Thies CO, Trampuz A. Meta-analysis of sonicate fluid in blood culture bottles for diagnosing periprosthetic joint infection. J Bone Jt Infect 2018, 3 (5):273-279. [CrossRef]

Disclaimer/Publisher’s Note: The statements, opinions and data contained in all publications are solely those of the individual author(s) and contributor(s) and not of MDPI and/or the editor(s). MDPI and/or the editor(s) disclaim responsibility for any injury to people or property resulting from any ideas, methods, instructions or products referred to in the content. |
© 2025 by the authors. Licensee MDPI, Basel, Switzerland. This article is an open access article distributed under the terms and conditions of the Creative Commons Attribution (CC BY) license (http://creativecommons.org/licenses/by/4.0/).